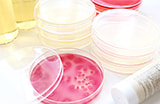
各検査項目に関して

お客様センターよくあるご質問・お問い合わせなど
STD研究所は、お客様とのコミュニケーションを大切にします。
さらに皆様にご利用いただきやすいサービスを目指し、ご質問やご意見を承っております。
ぜひお気軽にお問い合わせください。
最近よくお寄せいただくご質問
- 検査物はいつ採取してもいいのですか?
- 採取する時間によって、検査の結果がかわることはありません。
いつでもご都合のよい時に採取してください。- ご注意
-
- ・排尿のタイミングや生理の時期、うがい前に避けていただきたいことなど、詳細は器具説明書をよくお読みください。
- 自分で採血するのはこわくないですか?
- 痛みの感じ方には個人差もありますが、採血器具(ランセット)から針が出るのは一瞬です。
「間違って針で指をついてしまった」時などの感覚に近いと思います。
ちなみに、糖尿病の方が自己血糖測定をされる際に毎日ご利用されるような器具ですので、ご安心ください。
カテゴリーから探す
上記の内容をご覧いただいても解決しない場合は、
コールセンターもしくはお問い合わせフォームにて、お気軽にお問い合わせください。
STD研究所
郵送検査お客様センター
お電話でのお問い合わせ・ご相談
月曜日〜金曜日(祝日は除く)10:00〜17:00
メールでのお問い合わせ・ご相談
土・日・祝日のお問い合わせに対するご返信は、
翌営業日になりますのでご了承ください。